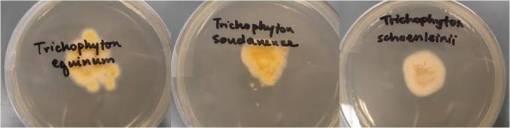
Trichophyton_3foreignspp

Forward
This essay is based on Benjamin Smith Barton’s statement about a geographical disease referred to as James River Ringworm which first appeared in writing in his Collections for an Essay towards a Materia Medica of the United States (3vols, Philadelphia, 1804).
The research questions presented for review are:
- What exactly was the James Fever Ringworm?
- Was it truly an endemic or epidemic disease like Barton suggested, or short lived?
- Why was it particularly common in not only in interior section of James River as Barton described but also along the shores according to French writer Louis Valentin?
- Where exactly did this disease along James River exist? Was it within the heavily populated sections of the river or in the more wilderness settings that are barely populated?
- Was it natural to the area, erupting mostly due to the increased number of settlers there and changes in land use and environment that took place?
- Or was it introduced by the first Europeans, or their Euro-America descendents, or other people that migrated into this region?
- Which population was impacted the most by it? Which population existed in the highest density in the region when this disease was an influence?
Obviously, if anyone is familiar with where I placed this essay on my blog, he/she could most likely hazard a guess that the answers to these questions relate to slavery and the in-migration of African people. The James River Ringworm epidemic was more than likely a consequence of the rapidly growing slave population in Virginia, and has political reasons for its introduction into this region along with cultural, environmental and biological reasons.
Origins of this Story
The story of how this epidemic was “discovered” relates to Thomas Jefferson. When he was a boy Thomas Jefferson grew up on a plantation his father had purchased and helped to develop. It was during his older childhood years and earliest professional years, the years during and after attending professional school, that Thomas would have learned about this disease, either by word of mouth and/or occasional visits to where the slaves resided.
When he was a boy, his family resided in the eastern part of Virginia close to James River in Tuckahoe and vicinity. In 1764, due to his father’s death, he was left with the entire farming business to deal with as new owner and manager. One of the primary crops for Virginia by now was tobacco, a crop of tremendous value in the marketplace. According to an associate of Thomas Jefferson from France, Louis Valentin, it was in 1766 that Thomas Jefferson first stated this story about the unique disease afflicting people in just this section of the interior country. Jefferson probably saw several or more numerous examples of afflicted by it in 1766, enough for a botanist from Philadelphia, Benjamin Smith Barton, to learn about it and the use of a local plant for treating this skin disease.
Letters from Th. Jefferson to Doct. Benjamin Smith Barton
Throughout his professonal years, Thomas Jefferson had numerous conversations with Benjamin Smith Barton. It was during these years that a major interest had developed between botanists and Jefferson regarding the potential uses for American plants as medicines designed to treat specifically the diseases of the United States. Although not a physician himself, Thomas Jefferson had the opportunity to learn much about medicine during the late 1790s and very early 1800s. It was a traditional practice for the first American authors of medicine of these years to gift a copy of their newly scribed book to Jefferson once it became published. This meant that Jefferson had plenty of opportunity to become familiar with the status of the field of medicine at this time, enough to recognize the uniqueness of the James River Ringworm epidemic taking plae on his family’s property.
By 1798, a very strong belief evolved that claimed medicine was a skill that was best learned locally, not by physicians and surgeons practicing and living abroad at the much more prestigious schools in Europe. For this reason, locally trained doctors were favored, and the James River epidemic presented an example of why this was the case. This nationalistic sense about medicine was new to this country, and was due in large part to the heavy dependence we had upon European exported medicines and European manufactured patent or proprietary medicines immediately following the Revolutionary War. With the local plant medicine market now developing, and medical writers like Shadrach Ricketson teaching the country how to grow its own opium drug supply rather than realy upon Turkish imports coming from Western Europe, reliance upon American herbs was now becoming popular but not completely relied upon as of yet as the medical history of the Lewis and Clark Expedition tells us. Medicines like opium, peruvian bark, ipecac had their local substitutes, and ultimately these became the first plants in the United States to develop large followings, with opium grown by locals, Peruvian bark replaced by Dogwood, and South American Ipecac by Carolina Pink. A major reason for this reliance upon local plants had much to due with the patriotism-turned-regionalism now fully underway. This philosophy states that for local diseases, you needed locally grown native herbs, a direct product of the Homannian philosophy taught about disease and drugs back in 1720 by Johann Christoph Homann.
The encyclopedia website gives the following biography and history for Benjamin Smith Barton (link #2):
His father, Thomas Barton, attended Trinity College, Dublin; came to Pennsylvania in 1750; and married David Rittenhouse’s older sister, Esther, in 1753. Ordained in the Anglican Church, he worked with the Indians around Carlisle, and settled on Conestoga Creek. Benjamin’s mother died in 1774, and his father in 1780, leaving Benjamin an orphan at fourteen. Educated by his older brother, William, and at an academy in York, Pennsylvania, he early showed a liking for history, natural history, and drawing, but recurrent gout soon plagued his health. He commenced medical training at eighteen under Dr. William Shippen of Philadelphia. During 1785 he joined his uncle David Rittenhouse, commissioned to survey the western boundary of Pennsylvania. During the first of his two years (1786–1787) of medical studies at the University of Edinburgh, although twice ill, he won for his dissertation on black henbane the Harveian Prize, which he did not receive until about 1813. He had been made one of four annual presidents of the Royal Medical Society of Edinburgh and had been entrusted with a sum of the Society’s money, which he was unable to return before his departure. . . .
Barton’s “irritable and even cholerick” disposition with his colleagues, influenced by his gout, was no doubt worsened by the consciousness of the sum unreturned to the Medical Society. As his nephew, W. P. C. Barton, wrote (p. 283): “… the struggles he made in early life through the most discouraging, nay appalling influence of want, added to the direful ravages of disease—his subsequent elevation appears astonishing … . He whose mental exertions survive such a fate, and who perseveres through it, is not, believe me, a common man!”.
In 1789, at the age of twenty-three, Barton returned to Philadelphia to become professor of natural history and botany; in 1795 he succeeded to the professorship of materia medica, and in 1813 he added the professorship of the practice of physic to his already too busy life. For ten years (1790–1800) he served as one of the American Philosophical Society’s curators, and from 1802 to 1815 as one of its vice-presidents. In 1797 he married Mary Pennington, by whom he had two children, Thomas Pennant and Hetty. He visited Thomas Jefferson at Monticello in 1802, and revisited Virginia in 1805.
Most diseases found in a region were not usually considered to be just of the region where they were found. The primary “disease”, fever, became linked to a specific place because of its weather and topography, times of the year, and climate. Thus when analyzing the cause for “fever”, there were many types.
“Fever” was considered a disease of its own, not just a symptom of a much larger problem, which is the way we interpret fevers today. The theory back then was that any disease had the ability to migrate about the body and represent in some new form, like a fever later leading to a heart problem or worsening into a chronic lung problem such as tuberculosis or expressing itself on and off like in the form of asthma or pleurisy. The James River Ringworm to some physicians was a result of the local environment and your ability to live with it and adapt to it, or not.
Fever was sometimes taken to be an indicator of a much larger disease that could appear later in life. The fever that initiates a life of rheumatoid disease is quite different from the cyclical fever of malaria, or the deadly fever of bilious disease known as yellow fever.
In the case of the endemic disease noted by Jefferson, this disease appears to have progressed to worser states, infecting more and more people, but not really disappearing or turning into some other epidemic or endemic disease condition. What is written about James River Ringworm and what we learn about it lasted mostly from 1766 to 1820, with malingering memories of it as a geographic disease found in mid-19th century medical writings.
Euphorbia perfoliatum, from Andrew Anderson’s Dissertation (detailed a few paragraphs down)
The history of the Ringworm epidemic was pretty much kept from the medical books and later researchers like myself due to the nature of its plant remedy–Eupatorium perfoliatum. This plant served as a primary medicine for fevers, and much of the public’s attention to this plant’s uses remained focused on its value as a febrifuge. Commonly known as Ague weed and Boneset, these two names pointed to its most popular uses–for treating malaria and yellow fever. A number of secondary uses for the Eupatorium can be found as well, most for treating the symptoms somehow linked to fever-related illnesses such as stomach pains. Due to this, the use of Eupatorium for treating ringworm appears to be linked in some way to its value as a fever remedy, implying the ring worm may have been considered a disease linked to places where fevers can prevail, a geographical trait more than likely seen in the interpretations of the brackish water, smelly, miasma rich environments found all along James River and across its broadly expanding marshlands and wetlands found here and there across the river edge and flood plains.
In 1808, reflecting back upon his own adventures as a traveler of the young United States, Louis Valentin made mention of this association of James River ringworm with Thomas Jefferson in an essay detailing his memories of traveling this part of the country. Valentin provided evidence for a timeline of this disease as part of his retrospection on some of his accomplishments. The following article details this retrospection and provides us with some very important insights into Thomas Jefferson’s experiences pertaining to his family’s business and the initial discovery of the James Fever ringworm epidemic problem. It also tells us that the James River Ringworm was not a malingering disease contained in the region throughout the years of habitation of this region. The temporal clues provided by Valentin suggest this form of ringworm disease was an opportunistic disease that made its way into the region for unknown reasons, infecting its first individual followed by many others due to numerous lifestyle and work related experiences. Most likely this disease reduce in frequency and prevalence due to changes in the disease causing organism itself, although Thomas Jefferson’s hot water springs may have had an impact on the viability of the disease on the human body if used frequently enough. The most likely reasons for it’s reduction of elimination more than likely was due to changes in living practices for those most afflicted by it, or some simple biological and ecological process that made it more difficult for the organism responsible for this disease to remain alive and active in this part of the United States. Such changes might include changes in living quarters situations, changes in crowded work and sleeping spaces, or increased availability of clothing supplies so that clothes and other fabric materials such as bedding and bath cloths needn’t be shared.
What also can be told about this disease based upon French physician Louis Valentin’s writing, is that it was at least in partially able to survive in this setting for quite some time, long enough to create havoc for several generations of development and the industrialization of the tobacco and other farming industries in this part of the country. In geographic terms, due to the flow pattern of James River, this means that latitudinally, climate had much to do with the persistence of this disease and the ability of it to survive, and not spread much in either the north or south directions during these years, much less heading eastward back to the coastline communities, or westward over the Appalachian mountain ranges. This disease had well defineable geographic barriers preventing its spread, preventing it from impacting the more heavily populated Atlantic coastal communities and leaving the James River ecological setting. This means that unlike a claim made by Valentin, that ringworm could be found elsewhere in this part of the country, James River Ringworm was its own unique geographical entity.
Translated:
I observed, indeed, on the coastlines of the country you live in, a fairly large number of persons affected with ringworm, mainly of the species called herpes squammosus and lichenoides. This eruption greatly reduces or even disappears completely during the hot, but it reappears in the winter and continues until late Spring. I think the food, almost constant, flesh salted pork, fish and shellfish remains in the low and very marshy places, and sudden changes in the atmosphere, throughout the cold wind Northwest, a little like what we experience at Provence, are the main causes.
This condition herpetic of the past is endemic to the inhabitants of the banks of the James River, and he [Barton] gave it the name of James River Ringworm. It usually occurs on the thighs, scrotum, anus, and it extends to the ravages till rectum, etc.. However, I learned that it has lessened, and has less victims than in the past, and that you are within reach of check [eliminating it]. Mr. Jefferson, President of the United States, informed Professor Barton, in 1802, that this scab of Virginia reigned heavily toward the year 1766, but has gradually decreased, since the mineral waters, like the warm and hot waters of Bath, which that State has become better known [for] and [now] most frequented. (The temperature of the first source is about eighty-eight degrees, the thermometer of Fahrenheit, and the second cell, one hundred and six degrees.)
.
The above note on Valentin’s writings confirms to us that this disease was perhaps first observed in association with the Jefferson family at their Plantation on James River sometime prior to 1766. Exactly when it was first noticed is not known at this time, but might be mentioned in the early Jefferson family papers [need to review!] In his earlier noted memoir, Valentin mentions this disease in respect to his recommendation that a local plant along the river edge be used to treat this epidemic–Water Hemlock or Conium maculatum. But as the medical journals reveal to us for years to come, another local herb became the more popular remedy for this problem–Eupatorium perfoliatum. The writings for this use of Eupatorium enough additional evidence about the behavior of James River Ringworm to help us determine more about its cause(s) and natural history.
A still better summary of these few discoveries made about Eupatorium and Ringworm appeared decades later in the 1846 edition of The Medical Times published in London. This article makes brief mention of the use of this plant for treating James River Ringworm, but like other writings is focused on the uses of plants for treating the various fevers (a more legible transcript of the pertinent section follows the figure).
Transcription:
The eupatorium perfoliatum has been used in other cases. It is said to have been found very useful in a peculiar and distressing herpetic affection which was formerly very common in Virginia and then known by the name of the James river ringworm because it was especially prevalent among the inhabitants residing in the upper streams of James river, young men were most liable to it. It attacked the thighs and scrotum and especially the parts immediately adjacent to the anus and its ravages extended into the rectum and perhaps further It was at all times a disgusting and troublesome disease but rarely proved fatal Mr. Jefferson states that this form of herpes has become much less common since the famed hot springs in the County of Bath in Virginia came to be much frequented. The decoction of the eupatorium perfoliatum was found very useful in its treatment. Dr. Barton says it is sometimes puked it no doubt purged and in all probability it acted as a sudorific but by what quality it more especially operated in curing the disease he is unable to say. Dr. Zollickhoffer [sic] says among all the internal and external remedies that are employed in tinea capitis he considers the eupatorium perfoliatum far superior in point of activity and promptness of effect. He has used it in conjunction with the bitartrate of potash with the most decided and unparalleled success and has never found it fail. He attributes its influence to its general alterative property. To adults he gives the powdered leaves and for children prepares a syrup of the infusion made with the leaves of the plant. The dose of the powdered leaves he says is from twenty to thirty grains. Dr. Eberle does not exceed the smaller quantity of the infusion or decoction from two to four ounces may be given as a tonic. He has not any personal knowledge of its emetic properties. Dr. Thacher says the infusion of eupatorium has long been esteemed an efficacious remedy in bilious colic accompanied by constipation, the dose is half a teacupful every half hour until its cathartic effect is produced. It most be given cold as the warm infusion is apt to excite emesis .
In the above section, we are provided with still more details about the specific form of ringworm that was the James River Ringworm. Tinea cruris refers to the groin-centered infection that ensues, an condition which in its milder forms today is referred to as “jock-itch.” A photograph produced by a European dermatologist and available on the web, and an illustration taken from an older medical reference (Guggenheim collection, unidentified) demonstrate how this disease probably presented to those who came to visit and saw its manifestations, with or without its victims wearing their typical summer apparel.

Thomas Jefferson notes the value of the hot mineral springs in the County of Bath for treating this condition. Such a philosophy and its discovery was very much typical for the time, and represents another set of examples of how the earliest rendering of a philosophy of medical geography came to be (noted on my page about this essay by cartographer J.C. Homann). Homann defined the following four kinds of uses for Medicinische-geographische nearly 50 years prior to Jefferson’s experience with the Slave population (those pertinent to here are italicised):
a) Diseases are a consequence of a region, and the body’s response to that region
b) Medicines for these diseases are usually associated with this region
c) The cultures residing in these regions must adapt to making the best use of these medicines and other natural products
d) Each place has a particular set of natural and divine, or sacred, features assigned to it that relate to these particular health problems.
.
Several later published key references on medical botany strengthen these claims made by Barton and Valentin. These claims are in part a word-by-word reiteration of past writings (plagiarism wasn’t as much an issue back then), but also provided a little bit more insight into each of these claims.
William Zollicoffer, for example, links the Eupatorium to treating the ringworm specific to James River residents–Tinea cruris or tinea of the groin region. The work of Zollicoffer followed by mention of the work of Eberle pertain to the pharmacology of medical plants. One of Zollicoffer’s earliest works was on “Eupatoria Corollata” which was published in the New York Eclectic Repository.
Dr. Eberle’s work crosses a number of disciplines in medicine. He was also primarily a plant chemist and pharmacologist, whose influences extended much further into the 19th century writings than Zollicoffer’s. According to a number of Eberle’s published writings, his work focused almost completely on bitters and astringents and their relation to producing effective tonics and fever remedies. He noted vomiting and sweat to be the major courses of action taken by this plant on the body, and so adds little to the knowledge already known about its use in dermatological conditions during the late 1810s and 1820s.
Eberle’s work therefore provides us with important insight into pharmacological philosophy–knowing and understanding the way a drug works, based on the philosophy of how the body works. This in turn can be related to better understanding why Ringworm was more than likely a fever associated disease. Eberle believed that Eupatorium worked against the James River Ringworm in much the same way that it worked against the fever, due to cleansing ability by way of inducing the sweat, or diaphoresis, the same method by which Jefferson believed that the Hot Springs of Bath, Virginia could also heal this disease. According to Eberle, by forcing the body to exude such large amounts of water through its skin, we cleanse the tissues immediately below the skins surface like the ringworm, and help cool the body thereby eliminating the fever, and if this philosophy is stretched further, eliminating the subdermal causes for this particular ringworm.
This popular opinion about the use of Eupatorium as an herbal medicine, mostly for fevers but as an aside for ringworm, was also detailed in a dissertation on this subject composed by Andrew Anderson. As part of his requirements for an MD degree, he presented this summary of the plant’s uses in 1813.
Like most of the writers, Anderson’s work focuses almost entirely on the value of Eupatorium as a fever remedy. But since his essay is on the plant in general, he included the following section on the value of Eupatorium in treating James River Ringworm.
Note also how mention is made for the first time of the inhabitants residing in the “upper streams of James River”. This is a very important addition to this story. Until now we knew little about the exact location of this very geographic disease. The use of the term “upper” in upper streams is of course somewhat subjective in nature, but is enough to lead us into the next very set of important research questions in terms of defining where this epidemic took place:
1. what microorganism could have been responsible for this epidemic?
2. what features define the upper and lower sections of James River between 1816 and 1813?
3. how does this geography relate back to the demographic, ecological and topographical requirements of the organism responsible for James River Ringworm?

Over the next several decades, the history of the James River Ringworm epidemic was nearly lost due in part to its possible reduction in prevalence in the Virginia region where sensitivity to diagnosing it and the experience required for this were both fairly commonplace. In the above German writing, little mention is made about this disease, except to note it tends to disappear when increased amounts of cold weather are brought in by the upcoming winter.
[Translate the above?]
We see several other mid-19th century descriptions of the James River Ringworm history in some of the homeopathic materia medicas published three decades later. Each of these tales of Eupatorium and its history pretty much duplicate the story told earlier, and seem identical in most of the homeopathic references that make reference to both the plant and the natural history of James River Ringworm disease. Also note, this description of the areas affected by rash almost perfectly matches the earlier drawings of how this full-fledged form of “jock-itch” appeared on young males back during the late 1700s and early 1800s.
.
One final mention of the use of Eupatorium as a remedy has to be made because it demonstrates the long lived direct link this herb has to treating dermatological condition, even after they were separated from the fever related conditions they were once so closely linked to by early physicians. Throughout the nineteenth century Eupatorium retained its materia medica value as a febrifuge mostly, with the one exception noted in a medical specialty book published in February 1881. This book referred to Eupatorium in its formulary section as a cure for particular skin diseases. The author of this materia medica termed the skin disease type that of “eczema”, a result of the problem physicians had with delineating the causes for the microbial based diseases. Until the organism responsible for it could be found, it was often linked to seemingly unrelated diseases of other types, such as the link drawn between fungal-derived ringworm and the typically autoimmune-derived psoriasis. Neither fungus nor autoimmunity antobodies had yet to be discovered in 1881, the earliest years of the bacterial theory for disease. In this statement by the author, we are stilled provided a very distinct and well localized geography for this particular form of ringworm.
Based on the above historical review, we are left with the following Research Questions:
1. what microorganism could have been responsible for this epidemic?
2. what features define the upper and lower sections of James River between 1816 and 1813?
3. how does this geography relate back to the demographic, ecological and topographical requirements of the organism responsible for James River Ringworm?
The next sections of this page review these research questions.
The first question requires a review of the possible organism responsible for the disease, including the ringworm diseases noted to be foreign born, due to the possibility of intercontinental transportation of such a disease due to its link to slave trade history.
To answer the second question I reviewed the places where slaves resided in Virginia between the original years of this trade (ca. 1630s) and the era when the Jefferson Family began its large family run plantation business in Virginia. The assumptions made here are that a) this is more than likely Jeffersonian in history due to its discovery by Thomas Jefferson and the family’s history of slavery and plantation farming, and b) the distribution of the Jeffersonian plantations will pretty much relate to other plantation farmers with much less, smaller businesses, meaning they are important, but not essential to understanding this part of the spatial pattern for plantation farms. The James River was heavily relied upon by Jefferson for establishing plantations; the same would be true for other farmers. The towns and villages found on the maps for this time not only interacted with Jefferson’s farms, but also the products of farms from others in the region, so Jefferson’s plantation geography is fairly representative of these remaining establishments as well. Whatever the case, since Jefferson knew about this unique epidemic history, it is assumed he was directly related to its history and geography, and/or had special knowledge about both of these unique local features.
The last of the above three questions was used to design the spatial analysis of James River and apply this information to what we know about the settlements occupied by African slave workers.
From the third question arose is a series of new questions, mostly of a geographical, methodological and mathematical nature. A number of maps were developed for this study of James River Ringworm, illustrated in the final sections of this page. Several spatial arguments were also applied to this analysis, including the sequent occupancy method of analysis used to form a proof for these findings, a brief ecological synopsis, and the development of a statistical equation used to assign risks to each of the possible sites for where tinea cruris erupted, with which the most likely place matching all the descriptions and requirements for James River ringworm cases was then identified.
One other step is required as follow up on the summary drawn from these steps. A fairly extensive review of the Jeffersonian documents and related papers for his associates is needed to see what other comments about this disease and/or its related, allied diseases were made. This might also shed light on how and why an associate well north of the James River watershed had knowledge about a treatment for this disorder published much later, noted by the very last image found on this page.
The Disease itself
So how did this disease present?
We know from enough descriptions that this presented as a groin disease, mostly in men, residing in the state of Virginia. The fact that it is referred to as ringworm suggests its similarity with the well known ringworms for the time, namely those of the scalp, body and feet.
What made this ringworm different was where it affected people, and the different appearance it had for this particular group of people.
At the beginning of the section of writings made by Valentin, detailed above, is written:
I observed, indeed, on the coastlines of the country you live in, a fairly large number of persons affected with ringworm, mainly of the species called herpes squammosus and lichenoides.
Referring to his various travels about the United States during its yellow fever years, Valentin’s mention that ringworm is found elsewhere in this country is true. But notice he does not split it into the various types commonly referred to today, or even back then by some physicians. So what Louis Valentin is probably referring to when he states that the ringworm is found all along the coastal communities is ringworm in general (and its various lookalikes for the time perhaps).
The unique presentation of James River Ringworm as mostly, if not only, a groin problem seen mostly in men, is what made it unique enough to earn its special geographic title.
Based upon the rising and then ebbing of this epidemic, we are left to wonder still, is it native and endemic, or is it introduced and for a short while recurring and seemingly endemic, or is it totally foreign in its origins and introduced, and short lived as an epidemic disease. But even more, we have to ask also whether or not this disease is of some animal-born or zoonotic nature. It is also possible hat this disease came in with livestock first, and infected people later as then settled on their new properties.

Ringworm has specific forms and species that are very well defined in regional distribution, and in living condition types. Most tinea conditions affect the body from the waist up. Some have different patterns of infection. Their species often defines where they came from. One of these tinea-causing species is restricted to Great Britain, another to Southeast Asia. There are also several species considered worldwide in distribution, but as of today (they may not have been global back around 1800).
Since much of the geographical evidence for this disease suggests it developed in a state rich in African culture and residency, in a location more common expected to be African-Slavery related in nature and population requriements, it is reasonable to assume here that the disease is more than likely a result of African importation, in particular the import of a slave which displayed little to no sign of infection or any related reason for removing him from those selected to live this sort of life. And so it is assumed here that any ringworms considered typical and definitive of African cultures would have been searched for in potential slaves, to either retain him or her, or remove him or her from such services 9see the tinea imbricata example in the pictures bleow). Any medical condition would have been good reason for not taking on someone for his/her services. Perhaps the least likely (not unlikely) form of tinea disease to be caught as part of the pre-sales inspection, would have been a very early stage of tinea cruris.
For more on the Tinea imbricata, see the End Notes section. The center image is interesting because it almost resembles the portrait of a famous politician. The most common bacterium responsible for Tinea cruris, T. rubra is in the petri dish to the right.
So suffice it to say, that of all the forms of tinea there are in the medical journals, and their causes, we can quickly narrow down the organism responsible for this disease to one that produced groin irritation.
Epidermophyton
There are only a few possibilities, namely
- Echinophyton
- Trichophyton
- some forms of Candida
Wikipedia gives the following
Excluded from this list was another source often mentioned, Microsporum, due to its lack of tendency to infect the groin. The Trichophyton mentagrophytes detailed above is closely associated with domestic farm and house animals, and therefore has some associations with pattern of land development locally and living styles (sequent of occupancy thinking, as detailed later). Epidermophyton in primarily a human-bound (anthroponotic) condition. Candida is ubiquitous, so ubiquitous in fact that it is expected to be the most widely spread form of the above four species induced disease patterns, and currently is very atypically groin-centered. (Rule out candida?)
Trichophyton
.
For the Trichophyton species, the following relationship exists between anthroponotic (human-bound) and zoonotic (animal-bound) diseases involving tinea or roundworms. Wikipedia was used for the zoonotic part of this review, and notes the following animal/human associations with Trichophyton species.
…………………………………………………………………………………………
| Trichophyton ajelloi | geophilic |
| Trichophyton concentricum | anthropophilic |
| Trichophyton equinum | zoophilic (horse) |
| Trichophyton flavescens | geophilic (feathers) |
| Trichophyton gloriae | geophilic |
| Trichophyton megnini | anthropophilic |
| Trichophyton mentagrophytes var. erinacei | zoophilic (hedgehog) |
| Trichophyton mentagrophytes var. interdigitale | anthropophilic |
| Trichophyton phaseoliforme | geophilic |
| Trichophyton rubrum | anthropophilic |
| Trichophyton rubrum downy strain | anthropophilic |
| Trichophyton rubrum granular strain | anthropophilic |
| Trichophyton schoenleinii | anthropophilic |
| Trichophyton simii | zoophilic (monkey, fowl) |
| Trichophyton soudanense | anthropophilic |
| Trichophyton terrestre | geophilic |
| Trichophyton tonsurans | anthropophilic |
| Trichophyton vanbreuseghemii | geophilic |
| Trichophyton verrucosum | zoophilic (cattle, horse) |
| Trichophyton violaceum | anthropophilic |
| Trichophyton yaoundei | anthropophilic |
…………………………………………………………………………………………
.
The Geography of James River Ringworm

.
Thomas Jefferson’s family was one of the two greatest importers of slaves in the 1700s and early 1800s. This has caused quite a controversy over the years due to his association with a young lady, who bore their child, and a simple review of the numbers of Africans he made use of on his plantations.
A list of Slaves for Thomas Jefferson’s Plantations
This large number of slaves on Jefferson’s property immediately points to his people as a possible source for the James River Ringworm he spoke about with Barton, and may have even been a disease that was imported since it tended to diminish in just a few years. It was this observation that in fact led to my review of the history of this unique form of Tinea, known as tinea cruris and today referred to colloquially as “jock-itch”. The form of tinea of the groins these slaves suffered was obviously more common and greater in severity and presentation for the population that suffered from it. Their location on the more upper parts of the James River suggested they were distant from Thomas Jefferson, but not completely out of touch with the overseers he hired for managing the farms. To better understand this possible scenario, a typical geographic approach was taken to answering the main research question–which is
what is the natural history of James River Ringworm, or in other words, where did it come from and why did it go away?
There are two distinct sets of questions that must be answered in order to define the exact cause and nature of the James Fever Ringworm disease.
Place of Disease
- First, did the disease occur in the more highly population portions of James River, close to the east coast of the Atlantic, where the heaviest populations resided?
- Second, as an alternative, did the disease predominate mostly in the western most portions of the James River waterways, in particular within the least population regions at the far west edge of the state of Virginia?
Nature of Disease
- Was the ringworm disease natural to the local ecology of the region?
- Was this possibly a form of ringworm brought in with in-migrating people, in particular the African slaves, which played important roles on the local plantations?
A fifth question helps to pull these two sets of questions together:
- How dependent was this disease dependent upon people to be spread or to develop into an epidemic?
This leaves as the remaining research question:
- What “animalcule” was this James River Ringworm due to?

Population Geography
The following summarizes the population density pattern for the james River region in 1776. This would have been 10 years into the introduction of James River Ringworm into this year, or one decade into its first notice as a disease pattern by Thomas Jefferson.
The Three Main Population Density Areas for African Slaves along James River, based on the 1776 Population map (data from the previous maps were merged; the borders or margins are indicated by dark green, medium green polygon areas and the green dotted line to indicate the hinterland boundary)
We can begin this review of population density and disease based upon one major assumption.
Thomas Jefferson was familiar with the disease due to its proximity to his family plantations, but not so close as to be in Monticello area, where the bulk of his family life was spent near and occasionally on these sites.
.
The following series of four maps, were pulled from Sylvest-Sarah Heritage Oak website (http://www.sylvest-sarah.com/maps.php) where the following authorship information for these drawings are provided: “Map showing the Virginia Plantations associated with Thomas Jefferson”- drawn by Bernetiae Reed 2006. (I added the blue line border and two bottom citation text notes.)
.
Monticello and Indian Camp areas, referred to as “Monticello” and “Indian Camp” for this research
Lynchburg-New London Area, known as “Judith’s Creek” for this study
Indian Camp Area, “Indian Camp”, “Willis Camp” and “Limestone” are also shown
.
Investigating the Sylvest-Sarah/Reed maps above, the following cluster patterns (in blue) were defined for these plantations related to or owned by Thomas Jefferson. Several ‘clusters” are actually single town/plantation units, serving as connectors between the major clusters for this study. The important highlighted connectors are Limestone, Natural Bridge (to the furtherst west point), and Tuckahoe, Turkey Island and The Forest further east along the estuary-inlet portion of James River. (These latter 3 spots are excluded from much of the following discussion.)
Major Slave Population Clusters (above)
Again, the assumption being made here is that the density of the slave population had much to do with the documentation of James River Ringworm by Barton. The Jeffersons had some of the largest farming tracts with at least 5000 acres in their possession when Thomas was born. The locations of these settlements would play a major role in the locations of in-migrating people, the presumed source for this particular ringworm infection since few other notes indicate it to be common elsewhere in the state much less the mid-Atlantic region.
.
Human Geography
The geography of settlers in Virginia play an important role in the story of this disease, and how the human geography or demography of Virginia evolved and changed over time is crucial to understanding Thomas Jefferson’s experience with seeing the first areas infected with this particular ringworm. The following is a county map depicting African (slave) population density in 1776. This is derived from the very first map covered on this page, and has redefined the areas (in green) into four distinct areas, ranging from urban to developed but not as dense in population, to countryside, to uninhabited/pioneer settings; this terminology in part mimics the terms used to define regions using the sequent occupancy model. Thomas Jefferson’s plantations and associates’ slave settings are overlain onto this map in red.
Transfer and Overlay of Plantation Clusters onto the demographic density-hydrology map of this part of Virginia
The depiction shows these sites are in the moderately to lightly populated areas, with two sites in the perimeter based upon the 1776 map. (Remember, Jefferson’s first notes about the disease in question was ten years earlier that this map, in 1766, when his family first began residing in Monticello.)
The following is a map of the African population for 1800, notice how the center of these immigrants has changed locations significantly.
The greatest numbers are now along the South Fork off the James River (Area 3 in the above illustration), involving an area immediately adjacent to the Indian Camp cluster area and its adjacent towns and villages and numerous plantations. The coastal and bay city populations once rich in slaves have now reduced in terms of rank-order relationship with all other areas. This implies a continuous active in-migration of slaves along James River, especially South Fork, at least for some period before the 1800 census was taken, with a related change in slavery employment from the domestic, farmland and basic labor settings to the more rural agricultural, early industrial settings, with some of the located off the beaten path. The largest settlements were the furthest away from Monticello, in terms of water transportation routes.
Physical Geography
It helps to understand the basic topography of Virginia before going into the final chapter in this history of James River Ringworm. For this reason the following notes and maps are added. These maps will be referred to in parts of the later discussions and summary.
Main imporatant features to review are:
- Landform/Topography
- Climate/Weather?
- Hydrology
- Geology/Pedology
- Ecology/Vegetation
.
.
.
Notes based on above figures:
.
.
.
Disease Diffusion Processes
Based on the layout of the plantation clusters, we can begin to develop several scenarios about the James River Ringworm spatial behavior. The two ecology related possibilities are that
- the ringworm is natural to the environment, or
- it is temporarily natural to an environment where it remains isolated for a short while, rarely making its way to the more densely populated regions.
This makes it a disease of opportunity, infecting mostly the denser populations in its isolated regions, namely the friends and acquaintances of slaves or other workers who carry it.
The following maps depict the steps in evaluating this disease transmission or diffusion process, with the first series (5 of the 6 maps) focused on an introduction of this disease into the region and how it might behave spatially following that in-migration.
The last map depicts how an endemic organism native to the area would behave and diffuse towards the other plantations and the more populated coastline region as implied by geographer Valentin.
.
Starting Map (for copying and taking notes on)
.
.
.

.
.

(Also note, Monticello was not built into the major homestead it is known as until the 1770s, but the cases reviewed for this study are from about this time or later, so this may not matter.)
.
.
We can apply some of the Sequent Occupancy philosophy and Disease types according to Gerald Pyle’s philosophy to this information to better understand its behaviors and possible cause(s).
.
The above identifiers will be used to try to quantify the risk of each cluster or point area labeled. Presumably, using the right quantifiers, we can see where the disease is/was most likely to develop along the river transportation routes. This step may not be necessary based on the ecological and topographic reviews above, but this step does help to define a statistical way to analyze this kind of situation through numerical analyses using a GIS.
The following names are used for the above numbered sites:
- Monticello (named for central most site in terms of authority and hierarchy)
- Willis Creek (named for first site contacted of the two)
- Indian Camp (named for first site contacted)
- Limestone
- Judith’s Creek (named for first site contacted)
- Natural Bridge
.
The above depicts a non-hierarchical diffusion process for this disease. The in-migration patterns is linear and ordinal. The order of events or chain of contacts made can help us to understand even better how a disease theoretically behaves in this situation, and then use this information to determine where the “outer rivers” part of this disease distribution must have existed. This is where this disease was witnessed first by Jefferson and perhaps later by Barton.
.
.
Diffusion Types
There are three diffusion types that Gerald Pyle infers by his writings Type I, II, and III.
Type I is a radial diffusion process, or in the case of transportation routes with limited branching, linear and ordinal in nature.
Type II is a hierarchical diffusion process, in which the order of travel is from the primary locations (most populated, densest, etc.) and from there on down in size usually.
Type III in Pyle’s rendering is a Mixed Model of these two, where hierarchy defines the introduction, but linear-radial behaviors define the remaining diffusion from that point on.
(Types II and III may be reversed in some descriptions.)
About 15 years ago I added to these models the Reversed Hierarchical diffusion process, in which hierarchy defines the “rich” so to speak and so reversed hierarchy is based mostly upon the “poor”, implying that due to poverty, the disease begins to impact people, and from there gains the momentum needed to diffuse into more populated regions, impacting even the middle class on up to the rich.
Finally, there is that ecological model of diffusion I discussed earlier on this page, the one in which it doesn’t matter what types of people are there, the diffusion process occurs as a natural even leading from one place to another, like in the case of ringworm that is zoonotic in origin, converting from animal borne to human born, an example of disease transmission that could involve any of the Trichophyton species noted on the above listing. Due to the “wilderness” requirement, animals and all, this model in some ways resembles the reversed hierarchical model.
If we look at the diffusion of Lyme disease in the Hudson Valley for example, suburban settings were their primary sites due to a combination of trees and forest edges and wildlife as prerequisites for high risk areas. In the case of west nile, ecological features played the most important role in the beginning, but modified land features was important since the vector species was very much human focused.

Typical Non-hierarchical diffusion process
Non-Hierarchical Order
Linear diffusion, nodal migration, Type 1 diffusion:
Nodal order:
- Perect linear, from east to west along logical waterborn travel routes, lacking barriers to diffusion, with diffusion time based soley upon distance, not resistance.
- 3 + 2,1,4,5,6 –> 2 –> 1 + 4,5,6 –>4 –> 5 –> 6
Theoretical Hierarchical Diffusion path, from Port to Monticello (main quarters), to second largest site (area 3. Indian Camp and neighbors) simultaneously travelling linearly to other largest site (area 5, Judith’sCreek), perhaps infecting smallest points along the way (areas 2 and 4), or not. thereby infecting these later.
Hierarchical Order
Hierarchical Diffusion, Type 2 diffusion:
Nodal order:
- From Monticello, outward to immediate then secondary contacts. Distance dependent mostly, without any assumed resistance.
- 1 –> 2 –> 3 + 4 –> 5 –> 6
- (probably not 2 –> 5 –> 4 + 6)
.

West to East Linear, or Reversed Hierarchical Diffusion pattern (from hinterlands to urban centers, see my thesis for more on this social inequality/socioeconomic defined diffusion pattern)
Reversed Hierarchical
Endemic, native, origin 6:
- From west to east, along two forks to the primary river. Distance dependent mostly, without any assumed resistance
- 6 –> 5 –> 4 –> 2 –> 1 + 3, or 1 –> 3.
Endemic, native, origin 5:
- Excludes area 6 as an option due to hinterland features of: climate/weather, low population density, degree to which cases were noted, land use, lack of additional sites (villages/plantations) in close proximity, geological-soil features, topography, etc.
- 5 –> 6 + 4 –> 2 –> 1 + 3, or 1 –> 3.
.
Cluster Comparisons
Using a cluster comparison method we can develop a predictive modeling tool for monitoring the James River Ringworm. Up till now, the assumption is that this disease has primarily impacted the slave communities. More than likely it either has or will strike other areas and so we need to know where. The following method assigned various levels of risk to a place or cluster based on several features evaluated for each site. These metrics can be ranked and/or ordered, assigned a value or score for their relevance to a disease being impacted by their presence or not, and then a risk score assigned to each site based upon what it has and what it is missing.
Our natural behavior often leads us to add these scores for each metric together. But in the long run the best way to utilize scoring methods like these is to rely upon multiplications first, additions or subtractions second, and then logarithmics when either the final scores seem to big and too distant from each other to present the results for, or in some cases, present a truly combined additive-multiplicative relationship.
In my development of a metric for evaluating people’s health in relation to metabolic syndrome, with its individual components reviewed separately such as amount of overweight a person is, blood sugar or HgA1c levels, hyperlipidemia and BP readings, I found that metabolic syndrome is a result of these sub-components and is not to be used as just one additional additive features; i.e. the best formulas for this case is (BMI (for Wt) + HgA1c + HL + BP) x Metab Syndr score, not all components simply added together–the Metab Syndrome score is multiplicative not additive in terms of making a person unhealthy.
For James River Ringworm, the major measure here is of personal hygiene in relation to healthiness of living conditions and living habits. Physiographic features that could be added as metrics include proximity to water body, average amount of humidity prevailing in a particular place, amount of coldness a person experiences since living in cramped quarters causes the cases to resurface in the wintertime, and overall rainfall and water features since water bodies give reason for the disease to be spread even more, such as between swimmers.
The following is a simple example of how the data for a series of sites can be evaluated and used to produce a risk score for this disease. In this case, log values are not necessary (they are usually essential when cost or $ values are involved, such as cost for service metrics and the like). This can be applied to any series of metrics and used to both explain and predict human behaviors and public health results. I used this example to define the most vulnerable cluster for the ringworm, in order to determine where the cases Jefferson heard about most likely happened. It could also be applied for determining where the next cases are most likely to erupt, assuming there are not other straggler sites out there that could suddenly pop up on the map the next time we evaluate the region for disease presence.
Descriptions
- Area 1. Monticello. Light Population 1776, Moderate Population 1800. Plantation [P] Cluster size = 7; Town/Village [TV] Cluster size = 2; Cluster strength (P x TV) = 14. Piedmont Plateau-Outer/Inner Piedmont. Karst Region 4-outer. Population rank index = 1 x 3 = 3.
- Area 2. Willis Creek. Moderate Population 1776, Moderate Population 1800. P Cluster size = 2; TV Cluster size = 1; Cluster strength = 2. Piedmont Plateau-Outer/Inner Piedmont. Karst Region 4-inner. Population rank index = 3 x 3 = 9.
- Area 3. Indian Camp. Moderate Population 1776, Heaviest Slave Population for State 1800. P Cluster size = 4; TV Cluster size = 3; Cluster strength = 12. Piedmont Plateau-Outer/Inner Piedmont. Karst Region 4-inner. Population rank index = 3 x 5 = 15.
- Area 4. Limestone. Light Population 1776, Moderate Population 1800. P Cluster size = 1; TV Cluster size = 1; Cluster Strength = 1. Piedmont Plateau-Inner Piedmont. Karst Region 4-outer. Population rank index = 1 x 3 = 3.
- Area 5. Judith’s Creek. Light Population 1776, Light to Moderate 1800. P Cluster size = 4; TV Cluster size = 2; Cluster Strength = 8. Piedmont Plateau-Inner Piedmont. Karst Region 4-outer. Population rank index = 1 x 3 = 3.
- Area 6. Natural Bridge. Less than Light Population, Light to perhaps Moderate 1800. P Cluster size = 1; TV Cluster size = 1; Cluster Strength = 1. Blue Ridge. Karst Region 3. Population rank index = 1 x 1 or 2 = 1 to 2.
There are also three places further east along the River that are as follows:
P Cluster size = 1; TV Cluster size = 1; Cluster Strength = 1,
Their identifications are (from east to west)
- The Forest,
- Turkey Island
- Tuckahoe.
These places can serve as connectors or links (nodes) between the interior and the east coast bay entrance. They can impact in-migrating ships, and represent a linear or radial diffusion process. For diseases migrating out along James River, for example for an endemic disease natural to the mid- to farwest-Virginia setting, these may be the connection needed to reach coastline communities and larger urban settings.
Final Scores
Formulas:
- Cluster Strength x Population rank index
- Cluster Strength x Population rank index x Karst score ( 1 or 2)
Without Karst [with karst]:
- Area 1 – Monticello. 14 x 3 = 42. [42]
- Area 2 – Willis Creek. 2 x 9 = 18. [18]
- Area 3 – Indian Camp. 12 x 15 = 180. [360]
- Area 4 – Limestone. 1 x 3 = 3. [6]
- Area 5 – Judith’s Creek. 8 x 3 = 24. [48]
- Area 6 – Natural Bridge. 1 x 1 or 2 = 1 or 2. [1 or 2]
According to the above scores, with or without karst topography considered, Area 3 – Indian Camp is the most likely place for an epidemic to develop, followed by Judith’s Creek. Monticello and Judith’s Creek are fairly close in risk, but some hierarchical impacts are seen, since the route for the disease to Monticello never had an influence. Proximity to Jefferson’s family made for cleaner workspaces.
A review of Jefferson’s history usually describes the Monticello area in detail, with descriptions very much necessary due to his political positions throught life-his Monticello properties were very tidy.
The furthest place from his abode was Indian Camp and its neighbors, and this is possibly where maintaining order was a problem. (Where did his rebellious slaves, whom were executed, live?). By water, the distance to this site is twice as far as Judith’s Creek.
The addition features about Judith Creek that seem to reduce the likelihood for disease include its physiographic features; it is on the edge of a region where topography and weather patterns can influence the local ecology and in turn change the disease patterns.
Between Indian Camp and Judith’s Creek, Indian Camp is the most likely place to have this problem, based upon logic as well as the indices calculated above.
Ecological Modeling
We can also ecologically model the ringworm based upon the initial discovery that Eupatorium has some ecological behavior that related to James River Ringworm. This link between plants and disease is an older theory already well promoted by Homann’s work in 1720, and continued through the next decades and century becoming a part of the medical botany philosophy for the time in United States history.
Eupatorium lives in a region that extends well north of James River, into temperate regions that tend to be much colder. But as 18th or early 19th century medical topographers we would know that Eupatorium alone does not tell us where to expect this ringworm problem to erupt, it only serves as an indicator such a problem could happen. As taught by Hoffman, Valentin and others, we next have to rely upon latitude requirements for the diseases and the related seasonal temperature and humidity requirements, to better understand its spatial distribution. Finally, in order of their addition to the medical geography theories popular during the 1800s, it helps to consider such natural features as geology, pedology, phytoecology, zooecology and even solar aspect with the land surface to best define the most likely regions to be impacted.
In more recent decades, Russian geographers have mentioned the impoprtance of knowing the distribution of animal vectors. In the case of the disease in the farwestern country, we might even anticipate this to be the case if the circumstances are right, such as a ringworm coming off of a bear, moose, deer or even horse and subsequently infecting people. If this ringworm were born from the wild, we would have to consider where the animal vectors of its zoonotic version exist in the wilderness, and overlap with the edges of the pioneer and early industrial settings. This classic Pavlovsky-Voronov interpretation of the disease provides us with a fairly detailed disease mapping project, all to determine the ultimate human ecology cause, result and means for prevention.
We are left to produce a disease migration model that is anthroponotic in nature. Just how do population density and peoples’ biology and behaviors effect the flow of this disease. If people are an important part of this picture, the cause-effect relationship turns its focus on the slave population and their employers and business associates. In other words, a demographic approach has to be taken to analyzing this disease, ecology and all. If the clues continue to point to mostly the local animals, wild or not, then we are dealing mostly with just the ecological picture of its history.
The way medical geographers best accomplish this task is by using a sequent occupancy approach to define the disease patterns, their causes, and ultimately their future expectations. Slave history is a unique topic to apply sequent occupancy to. With a focused review of slaves and health using this approach, we start at an unusual part in this method of interpretation. By focusing on the African populations and its lifestyle patterns, not the American life experiences before and during the acts of hiring slaves and forcing them to work, we have a unique view of what life was like as a slave during this time. The United States interpretation versus the African interpretations of these events in life, as a part of the sequent occupance figure often accompanying my work may be, is as follows.
[chart]
Sequent Occupancy and Slavery
An interesting but very unfortunate thing about slavery is the role and placement of slaves in the sequent occupancy model. We don’t expect to see slaves appearing in this model until the development of farming industries and some small businesses located in urban settings. Slaves did serve a very important role in the domestic setting as well, but this was primarily for families with a considerable amount of income generated by a big family business. For this reason, the sequent occupancy model at first lacks much evidence for large numbers of individual residing in Stages 1 and 2. Of course this changes over time.
Unless the slave has been fortunate enough to experience manumission, it is unlikely that a slave will be found in the wilderness during the early stages of sequent occupancy. The nature of the occupation states that early farming/industry and advanced farming or agriculture and industry are required. This also implies communal living, close associations between people, moderately to heavily populated cluster patterns or regions and the increased likelihood that certain diseases with environmental and demographic features play important roles in the local health.
If we apply sequent occupancy to the above scenario, we can interpret the population density version of the map that is produced as an indicator of sequent occupancy stages, or we can treat each of the clusters separately from each other and try to interpret them as different stages in sequent occupancy. With this latter means of interpretation, the outlier communities and towns that act as communication nodes exist at some low lever in sequent occupancy (stage 2, since they are not wilderness settings), and the larger more heavily clustered aggregates bearing high risk scores existing as stage 3 places. With this point of view, we also find the regions to the east to be more advanced versions of stage 3 locations, with the coastal communities regarded as urbanized, industrial state 4 settings.
This offers us the opportunity to compare two types of slavery–that taking place in stage 3 settings versus the slavery roles and behaviors of stage 4 settings. The former is the agricultural/plantation settings, the latter being domestic and factory/work environment settings. The disease histories for each of these two types of slavery environments have different diseases attached to them, a result expected of state 3 versus 4 models in general.
The rest of this place-health-disease argument naturally follows.
In the state 3 areas we expect more farming accidents, in stage 4 urban settings we expect less farming incidencet and more domestic and factory related problems. These observations of course relate to the industry types that differentiate these to areas. But living style is also different between the two, so other diseases can kick in as well in one area but not in another, like the cholera epidemic tending to impact urban settings more often than rural settings, according to a hierarchical diffusion pattern. And the reversed hierarchical diseases taking hold of the farming land communities first before infecting the more heavily populated urban centers. These demonstrate valid applications of the above models to any study engaged in about people, place and disease patterns.
With all of this in mind, the following table sumamrizes the findings or implications for each of the six cluster areas reviewed with regard to James River Ringworm, to demonstrate where this disease fits in with regard to the evolution of human land use.
Applying Epidemiological Transition Theory
An important observation to note here is that epidemiological transition theory has played little to no role in analyzing the history of slavery and African medical history in the way that I presented it. The Sequent Occupancy method is more applicable to analyzing the health of African slaves, when small periods of change or transition are often involved. Whereas Epidemiological transition theory focuses on simpler statistics like lifespan and types of disease, typically at a large area or national level, the sequent occupancy model pays more attention to the details, adding notes detailing the smaller differences that exist between one level of culture and the next, one stage of development and the next.
Epidemiological transition is applicable to large political, country-based settings and condition for the most part, or for the use in comparing life, longevity and quality of life between two different time spans. Sequent Occupancy reviews the population in much finer detail, and does not require two different time frames, but simply two or more levels of economic development. This is a significant difference from the Epidemiological Transition model, which we are better off applying to this work once the Sequent Occupancy way of analysis is complete, perhaps as a more retrospective way of discussing the results.
[Comparison table]
Does this mean the slaves did not experience an epidemiological transition? No.
Did the slave populations demonstrate Epidemiological Transition? Of course they did.
When manumission changed their life history and made them residents of the United States, Stages 1 and 2 in the sequent occupancy model can now take place, and it did as many moved west to form pioneer settlements. The long term impacts of freeing the slaves also provides us with an opportunity to compare pre- and post-bellum slavory medical history, in terms of that much more broadly applied epidemiological transition theory. The epidemiological transition model can be used to compare today’s disease history with these two past periods, to better understand the changes that occur in population health over large periods of time. So the application of Epidemiological Transition theory is not out of the realms of possibilities for the questions we can ask. It is just that we learn a lot more applying sequent occupance theory first, before delving into the big picture.
In terms of understanding shorter periods of time with regard to medical, disease and epidemiological history, the sequent occupancy model is the best way to go with analyzing people and disease patterns. We cannot fit James River Ringworm into the epidemiological transitional model that easily or concisely. But we can make sense of it using the sequent occuapncy model. The Epidemiological Transition theory is not focused upon space, as much as it is on time. Sequent occupancy is applicable over different parts of space during the same period of time, or the same space over dfifferent periods of time, thereby making it more useful and flexible for spatial disease research.
.
The Human Geography/Human Ecology of this Disease
In the final part of this review of James River Ringworm as a disease phenomenon with a unique ecological and sociocultural history regard African-American culture, there are three classes of diseases a particular culture contends with whenever in the United States setting that have to be reviewed with regards to the slaves’ cultures.
There are culturally-bound syndromes which happen due to cultural beliefs, and require both the individual manifesting the condition and his/her onlookers to believe this condition is credible and true.
There are culturally-linked conditions, disorders, and diseases which are anatomically, physiological or otherwise biologically linked to a particular culture of people, not so much due to behaviors and emotions, although these often play important roles in the manifestation process, but due primarily to an identifiable physical trait, such as genetically different heart condition or some sort of hereditary-genetically linked comorbidity that sets in when an important event in life happens, such as a spouse’s death.
Then there are these culturally-related or likely conditions, syndromes and diseases that occur due to culture playing a role in their development and onset, with the possiblity that some of these circumstances leading up to the illness may be modifiable to some extent, thereby reducing the mortality rate of the condition, syndrome or disease. An example of this is the morbid obesity in Pima Indians, a medical condition with a very well defined genetic link, but with behavioral patterns that may effectively remove the problems related to this condition from becoming so severe (easier written than done however). Likewise, in Oriental cultures, it has been shown that their vegetable rich diet is good in some respects, bad in otehrs, and in the case of stomach cancer, some of their vegetables have a tendency to increase stomach cancers due to the chemical content of these unusual food sources. This too is preventible by a simple dietary change, which may or may not be easier said than done.
The Health Belief Model helps to demonstrate where these factors come into play with disease manifestations.
How this related to James River Ringworm is severalfold.
James River Ringworm is the third type of disease pattern.
The causes for epidemic/endemic prevailing disease events is linked mostly to human behaviors, taking place in the right environmental setting. It is not genetically induced like many culturally linked diseases are. It is certainly not culturally bound, like a religious belief induced disease state. It is simply a result of personal and social lifestyles.
The environmental setting, defined as warm tropical like temperatures in association with high humidity and water/swimming resources, sets the stage for this disease to become highly prevalent or not. The role of the human behavioral component in all of this pertains to how one behaves when he/she has this condition. In particular ,the sharing of fabric and textile wares [‘Likelihood of Action’ in the above] is a primary cause for its passage to new people; people do not perceive this as a threat, and certain cultural teachings promote this form of socialization. This means that sleeping materials, clothing, outdoor wear, shared work clothing, shared towels or linens next to the river, are all possible causes for the rapid dispersal of this condition to many other people, from just an initial victim, should this form of sharing rare commodities be a socially acceptible practice.
This same logic carries into sociocultural recreational and traditional activities. Should any social recreation or dancing be engaged in according to traditional African lifestyles, this sets the stage for passing the disease onto new victims. All of these help to make the infected region of James River likely to continue the life of this disease for more than just a year.
When we look at Valentin’s and Barton’s descriptions of this event, we find that it has a resurgence in the winter, suggesting again that close quarters in combination with shared clothing, sleep materials and even beds could be a cause for turning this simple disease into a camp-related epidemic.
The final major factor impacting how this disease behaves, and whether or not it goes away, pertains to simple hygienic practices. Indian Camp and its nearby facilities, due to their distance from Monticello, may have been more lax in their hygienic practices, making it possible for the disease to spread more rapidly.
Camps further west lacked some fo the natural settings needed to help promulgate and priopagate this condition, with the smallest two clusters very unlikely to manifest the disease for much longer than a few people, and just for one or two years if there isn’t much population turnover at these sites. If there was population turnover for two of them, the links to other sites, we’d expect this disease to display traditional miasmatic infectious behaviors, spreading from one cluster along a route to the next. Such is not seen between the long distance connectors, but remains very probable in the two largest clusters — Indian Camp and Judith’s Creek.
Reviewing the landscape and ecology for the time, it is important to note that the increased human population related to this disease by converting the James River area into a more densely population setting. Even though this setting is fairly rural in nature, being connected to the plantation lifestyle, we see possibilities for people interactions that can result in the diffusion of this disease into so many people, that it earns its recognition for being a local epidemic.
The James River Ringworm is different from other forms of ringworm infection noted anywhere else in this part of the country. Its peculiar and rather vicious presentation drew the attention of a number of people. At first, one might suspect something like impetigo as being a problem, or perhaps psoriasis and other skin conditions. But the specific anatomical behavior of this disease made it stand out, enough to be given a name of its own, to avoid mixing it up with the other more common forms of skin disease produced by poor living conditions.
James River Ringworm most certainly set this particular slave community apart from the rest, and with time probably allowed for some lessons to be learned by the Slave owners regarding keeping a clean camp or set of living quarters, providing enough clothing, sleep materials and work apparel, and making it possible for fairly regular cleaning practices to be engaged in by their servants. In spite of all of these lessons this simple, very common disease tauight to slave population, the non-slave population, the physicians, and present or future government officials like Thomas Jefferson, we hear little about these lessons directly, only see evidence for thier inferences made whenever we learn about effective preventive health practices being engaged in with regard to the slave population and its living quarters, non of which really appears in the literature that much regarding this disease.
A final note, without checking the history of Indian Camp, and without looking for other ethnic relationships in Jefferson’s plantations, we find that in general there has often been this problem with cleanliness in some cultural settings versus the others. This may or may not have also come into play here. Presumably, the James River Ringworm epidemic is a predominantly African culture disease problem, allowed to happen due to the typical mistreatment of slaves. The cultural differences between early and late slave places are also important to consider, Thomas Jefferson obtained his later slaves from a different part of Africa closer to the Gold Coast, whereas his first came from a region further south along the western edge of Africa. These cultural differences may have played a role in these findings as well. That possibility has not been fully checked.
NOTES & APPENDIX
.

.
NOTES
TINEA IMBRICATA
Left Figure notes: Malabar itch –> tinea imbricata.
An eruption consisting of a number of concentric rings of overlapping scales forming papulosquamous patches scattered over the body; it occurs in tropical climates and is caused by the fungus trichophyton concentricum.
Synonym: herpes desquamans, malabar itch, oriental ringworm, scaly ringworm, tinea tropicalis, tokelau ringworm.
Wikipedia
Known as “Malabar itch”, a skin infection consisting of an eruption of a number of concentric rings of overlapping scales forming papulosquamous patches is caused by the fungus.[2] It also causes athlete’s foot, ringworm, jock itch, and similar infections of the nail, beard, skin and scalp.
Source: http://www.biology-online.org/dictionary/Malabar_itch
.
POPULATION DENSITY
For remapped data.
- Rare Slave Aggregates (little to no aggregation) – beyond (west of) green boundary line
- Rural Slave Population (moderate to strong aggregation) -green boundary line
- Inland Slave Population (strong aggregation behaviors) – green
- Core Slave Population (high aggregation) – dark green
Aggregation implies infectious disease related findings can prevail. Infections may be transmitted by direct (person-to-person) or indirect contact (person-to-person aerial, vs. fluid or surface by means of fabrics, food, currency, tools and other objects, etc.) This is an exponential or multiplicative relationship (i.e. exponential: 1,4,9,16 [high] downward to multiplicative: 1,3,5,7, or 1,3,6,10) , not linear rank-order (1,2,3,4).
SINKHOLES (from http://www.inspectapedia.com/vision/sinkholes.htm)
Sinkholes are most prevalent in karst terrains, but they occur throughout Virginia. Karst terrains imply alkalinity and for most organisms, less inhabitability of ground water ecosystems (this relationship is opposite for vibrio spp.). Areas which may contain sinkholes [scores assigned for this study in brackets] are thus ranked as follows:
- Far Western State–Subsidence/sinkholes are related to mining activity or soil piping; [0]
- Western State–Karst, sinkholes are related to the dissolution of limestone and dolomite (refer to Hubbard, 1983 and 1988, for more detail) or soil piping [1];
- Central Ridge–Sinkholes are very rare and are related to soil piping [4];
- Central to Eastern State–Sinkholes are rare and are related to soil piping or dissolution of sparse carbonate rock [3];
- Eastern-Coastal State–Sinkholes are related to the dissolution of shell concentrations in sand and soil piping [2].
More information about sinkholes in Virginia, published by the DMME, is at Sinkholes in VA
Culpeper County, Virginia, Thomas Knox
Knox is situated far north of the James River area where the ringworm is said to prevail according to Barton. His knowledge of how to treat this problem using Eupatorium is therefore a curiosity.
Sources:
The Project Gutenberg EBook of History of the Negro Race in America From
1619 to 1880. Vol 1, by George W. Williams. http://www.gutenberg.org/files/15735/15735-h/15735-h.htm
Benjamin Smith Barton. Collections for an Essay towwards a Materia Medica of the United States. 1798, 1804. J.U. & C.G. Lloyd reproduction Series. No. 1 (text form). http://www.archive.org/stream/bulletinlloydli00unkngoog/bulletinlloydli00unkngoog_djvu.txt













































November 18, 2014 at 8:04 pm
Thank you for the very interesting article! You may want to point out that the 18th. century picture of boneset is labelled “euphorbia perfoliatum” even though it is clearly a picture of eupatorium perfoliatum. Evidently, “euphorbia” was often used as a synonym for “eupatorium” in the old days but today they are in completely different plant families. Plants in the euphorbia family are often extremely toxic–even topically–so it is important to tell them apart.